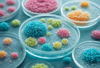

10-Year Follow-Up: Pembrolizumab Outshines Ipilimumab in Advanced Melanoma
Long-term study shows pembrolizumab's superior efficacy over ipilimumab for advanced melanoma patients.

Study reveals gut bacteria's role in immunotherapy outcomes for cervical and endometrial cancer patients.

Phase II/III trial shows cediranib/olaparib not superior to chemotherapy in platinum-resistant ovarian cancer.

Pembrolizumab plus chemoradiotherapy significantly improves survival in high-risk cervical cancer patients.

Meta-analysis reveals rucaparib's efficacy in treating recurrent ovarian cancer, especially in BRCA carriers.

Phase 2 trial evaluates PARP inhibitor and antiangiogenic agent in recurrent endometrial cancer.

Study compares sequential vs. combination immunotherapy in platinum-resistant ovarian cancer patients.

Phase III trial of ofranergene obadenovec plus paclitaxel fails to improve outcomes in ovarian cancer

Durvalumab plus chemo followed by durvalumab +/- olaparib improves PFS in advanced endometrial cancer

Study shows olaparib rechallenge improves progression-free survival in platinum-sensitive relapsed ovarian cancer